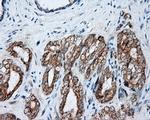
NME4 Antibody in Immunohistochemistry (Paraffin) (IHC (P))

Search
OriGene
NME4 Monoclonal Antibody (OTI1A5), TrueMAB™
{{$productOrderCtrl.translations['antibody.pdp.commerceCard.promotion.promotions']}}
{{$productOrderCtrl.translations['antibody.pdp.commerceCard.promotion.viewpromo']}}
{{$productOrderCtrl.translations['antibody.pdp.commerceCard.promotion.promocode']}}: {{promo.promoCode}} {{promo.promoTitle}} {{promo.promoDescription}}. {{$productOrderCtrl.translations['antibody.pdp.commerceCard.promotion.learnmore']}}
产品信息
CF501110
种属反应
宿主/亚型
分类
类型
克隆号
抗原
偶联物
形式
浓度
规格
纯化类型
保存液
内含物
保存条件
运输条件
产品详细信息
For reconstitution, we recommend adding 100 µL distilled water to a final antibody concentration of about 1 mg/mL. To use this carrier-free antibody for conjugation experiments, we strongly recommend performing another round of desalting. (Zeba Spin Desalting Columns, 7KMWCO, 0.5 mL, Product # 89882)
靶标信息
NME4 is a protein kinases, which are enzymes that transfer a phosphate group from a phosphate donor, generally the g phosphate of ATP, onto an acceptor amino acid in a substrate protein. By this basic mechanism, protein kinases mediate most of the signal transduction in eukaryotic cells, regulating cellular metabolism, transcription, cell cycle progression, cytoskeletal rearrangement and cell movement, apoptosis, and differentiation. With more than 500 gene products, the protein kinase family is one of the largest families of proteins in eukaryotes. The family has been classified in 8 major groups based on sequence comparison of their tyrosine (PTK) or serine/threonine (STK) kinase catalytic domains. The AGC kinase group consists of 63 kinases including the cyclic nucleotide-regulated protein kinase (PKA PKG) family, the diacylglycerol-activated/phospholipid-dependent protein kinase C (PKC) family, the related to PKA and PKC (RAC/Akt) protein kinase family, the kinases that phosphorylate G protein-coupled receptors family (ARK), and the kinases that phosphorylate ribosomal protein S6 family (RSK).
仅用于科研。不用于诊断过程。未经明确授权不得转售。
篇参考文献 (0)
生物信息学
蛋白别名: NDK4; NDP kinase D; NDP kinase, mitochondrial; NDPK-D; nm23-H4; non-metastatic cells 4, protein expressed in; Nucleoside diphosphate kinase 4; nucleoside diphosphate kinase D; Nucleoside diphosphate kinase D, mitochondrial
基因别名: NDK; NDPK-D; NDPKD; nm23-H4; NM23D; NM23H4; NME4
UniProt ID: (Human) O00746
Entrez Gene ID: (Human) 4833